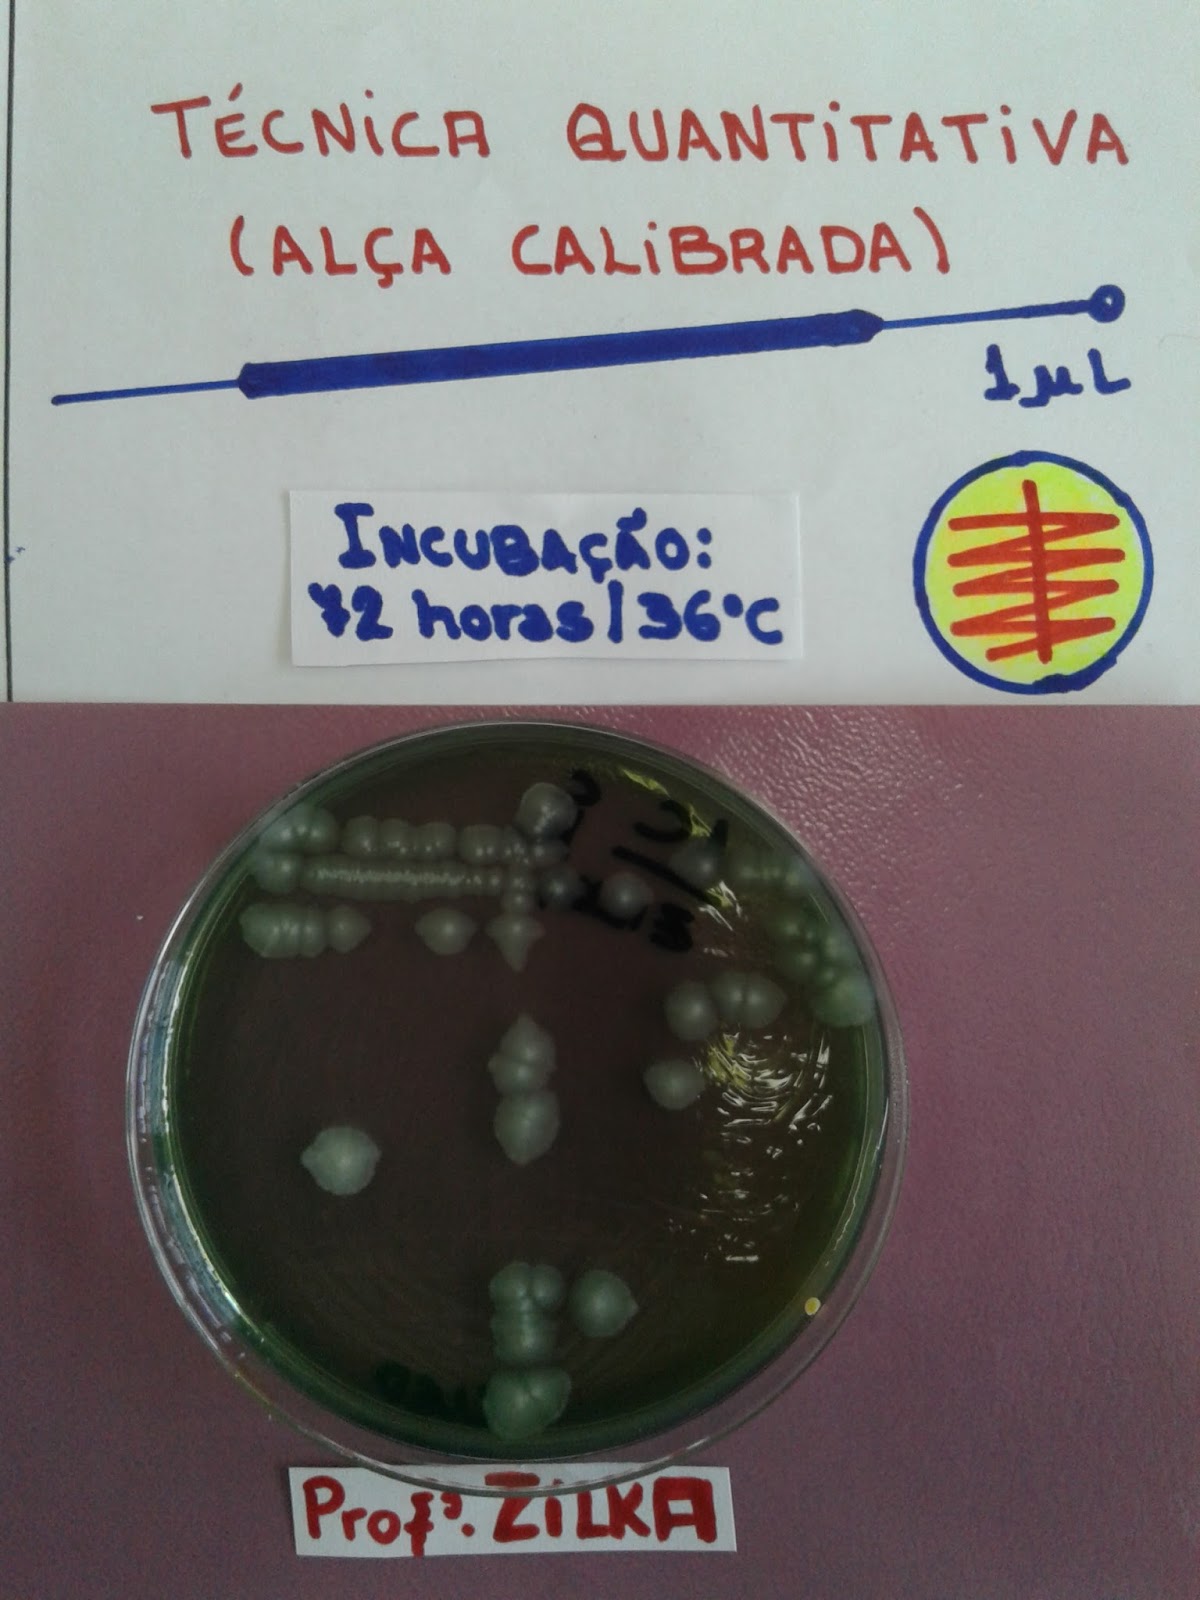
Resultado de imagem para of métodos de semeadura de colonia de bacterias

RELATÓRIO NÚMERO 1 DE MEIOS DE CULTURA E
CONDIÇÕES FÍSICAS DE CULTIVO
BACTERIANO
Sodré Neto
Jordânia
PROFESSORA CARLA AFONSO - UFG IPTSP
https://www.youtube.com/watch?v=F9wpgWYIw0o
Materiais, metodologia e resultados
Materiais
Placas de agar
Nutrientes e materiais para fabricar placas
Metodologia
Usando nutrientes nas proporções descritas no rótulo dos mesmos, aplicadas as devidas proporções (via regra de 3) , dissolveu-se em água destilada e levou ao aquecimento durante 1 minuto. Depois derramou-se o líquido gelatinoso ainda liquido nas placas , na capela, atrás de fogo aceso , esterilizando com fogo a boca do frasco, e passando fogo nas bolhas eventuais .
Tres métodos de isolamento de colonias foram apresentados
Resultados 

A) Meios de Cultura
Para o cultivo e identificação das bactérias são utilizadas soluções e substâncias nutritivas, denominadas meios de cultura que podem ser classificados com base na sua constituição, ou seja, quanto às substâncias nutritivas que os compõem, quanto ao seu estado físico e quanto à capacidade seletiva e diferencial que apresentam. Quanto às Substâncias Nutritivas:
1. Meios Sintéticos: quando as substâncias que os compõem são químicamente definidas e a concentração e características de cada ingrediente são conhecidas com exatidão.
2. Meios Simples: quando constituídos somente de substâncias essenciais para o crescimento de algumas bactérias.
3. Meios Complexos: quando se adicionam ao meio simples, substâncias orgânicas complexas.
B) Quanto ao Estado Físico:
1. Meios Líquidos: também denominados caldos.
2. Meios Sólidos: quando se adiciona ao caldo l,5% a 2% de ágar.
3. Meios Semi-sólidos: quando se adiciona ágar ao caldo, na concentração igual ou menor que 0,5%. Quanto à capacidade seletiva e diferencial:
1. Meios Enriquecidos: são meios simples adicionados de certas substâncias como soro, sangue, extrato de levedura, etc. Estes meios servem para o cultivo de bactérias que necessitam de substratos complexos. Ex: meios de ágar sangue, de ágar chocolate, de ágar soro, etc.
2. Meios Seletivos: são meios de cultura contendo substâncias que impedem o crescimento de certas bactérias sem inibir o crescimento de outras. Ex: Meios de MacConkey, de Tetrationato, de Verde Brilhante, etc.
3. Meios Diferenciais: são aqueles que contêm substâncias que, quando utilizadas, indicam certas características da bactéria. Ex: a) O sangue quando adicionado ao meio de cultura, indica se uma bactéria é hemolítica ou não. Nesse caso, o meio além de enriquecido é também diferencial. Ex: meio de ágar-sangue. b) A lactose quando adicionada ao meio juntamente com um indicador de pH, permite distinguir as bactérias que fermentam esse açúcar das que não o fermentam. Ex: meio de MacConkey.
4. Meios de Enriquecimento: são aqueles que inibem o crescimento de certas bactérias, porém favorecem o crescimento de outras. Ex: meios de tetrationato e de selenito permitem maior crescimento de bactérias do gênero Salmonella.
5. Além desses, existem outros meios de cultura, como por exemplo meios para conservação de bactérias, meios para a contagem do número de bactérias, etc.
B) Condições Físicas de Cultivo
Além do meio de cultura, outros fatores devem ser levados em consideração para o cultivo de bactérias, tais como:
1. pH do meio de cultura: deve ser geralmente em torno de 7.
2. Temperatura de crescimento: geralmente 37ºC Quando as bactérias crescem em temperaturas baixas (10 a 20ºC) são denominadas de psicrófilas. Quando as bactérias crescem em temperaturas médias (20 a 40ºC) são denominadas de mesófilas. Quando as bactérias crescem em temperaturas mais altas (50 a 60ºC) são denominadas termófilas.
3. Teor de Oxigênio:
a) Bactérias aeróbias estritas: são aquelas que só crescem na presença de oxigênio.
b) Bactérias anaeróbias estritas: crescem somente na ausência de oxigênio.
c) Bactérias anaeróbias facultativas: crescem tanto na presença como na ausência de oxigênio.
d) Bactérias microaerófilas: crescem somente em atmosfera com baixo teor de oxigênio.
http://www.ibb.unesp.br/Home/Departamentos/MicrobiologiaeImunologia/apostilabiomedicina.pdf
BHI 
O Agar Infusão Cérebro e Coração (BHI) é um meio para cultivo de uma grande variedade de microrganismos, incluindo organismos fastidiosos, leveduras e fungos.
Preparação:
Suspender 52 g de pó em 1 litro de água destilada ou deionizada. Aquecer até dissolver completamente. Esterilizar em autoclave a 121°C por 15 minutos. Resfriar entre 45-50°C. Dispensar em placas de Petri.
Aplicação: O Agar Infusão Cérebro e Coração (BHI) é um meio para cultivo de uma grande variedade de microrganismos, incluindo organismos fastidiosos,BD Brain Heart Infusion (BHI) Agar é um meio de utilização geral, adequado para a ... Sem suplementação, O ágar de infusão de cérebro-coração (BHI) , uma substituição ao meio BHI (Infusão de Cérebro Coração) bovino tradicional ... Propriedades de Apoio ao Crescimento: Resposta de cultivo no Ágar Peptona , Princípio de ação. O caldo BHI possui em sua formulação peptona e infusão cérebro-coração que servem de fonte de nitrogênio, carbono, enxofre e vitaminas ,Dissolver 52.50 gramas em 1000 ml de água destilada. Gentilmente aqueça até ferver com agitação suave e dissolver o meio completamente. Esterilizar por ... , A composição básica do caldo cérebro-coração (BHI) deverá ser a seguinte, por litro de meio: Infusão de cérebro de carneiro 12,5 g INSTITUTO FEDERAL , Os meios de cultivo indicados compreendem ágar Sabouraud dextrose acrescido ... pode-se semear a amostra também em ágar infusão cérebro-coração (BHI). https://www.adrialaboratorios.com.br/agar--infusao--cerebro-e-coracao--bhi--500g/p
ÁGAR SANGUE PRINCÍPIO ƒ
O meio de Ágar sangue, usando uma base rica como abaixo descrita, oferece ótimas condições de crescimento a maioria dos microrganismos. A conservação dos eritrócitos íntegros favorecem a formação de halos de hemólise nítidos, úteis para a diferenciação de Streptococcus spp. e Staphylococcus spp. UTILIDADE ƒ Usado para o isolamento de microrganismos não fastidiosos. ƒ Verificação de hemólise dos Streptococcus spp. e Staphylococcus spp. ƒ Usado na prova de satelitismo (para identificação presuntiva de Haemophilus spp.). FÓRMULA / PRODUTO ƒ Meio comercial: Blood Ágar Base, Columbia Ágar Base, BHI Ágar, Mueller Hinton Ágar; ƒ Sangue desfibrinado de carneiro ou coelho: ـ 5 ml para cada 100 ml de meio base. ـ pH: 6,8 +/- 0,2 PROCEDIMENTOS ƒ Pesar e hidratar o meio conforme instruções do fabricante; Esterilizar em autoclave; ƒ Esfriar a base à +/- 50ºC; ƒ Adicionar 5 ml de sangue desfibrinado de carneiro para cada 100 ml de base; ƒ Homogeneizar delicadamente para não formar bolhas; ƒ Distribuir em placas de Petri de 90 mm de diâmetro. CONTROLE DE QUALIDADE ƒ Hemólise beta hemolítica: Streptococcus pyogenes ATCC 19615 ou Staphylococcus aureus ATCC 25923. ƒ Hemólise alfa hemolítica: Streptococcus do grupo viridans ou Streptococcus pneumoniae ATCC 6305. ƒ Hemólise gama (sem hemólise): Enterococcus faecalis ATCC 29212 ou Staphylococcus epidermidis ATCC 12228. CONSERVAÇÃO E VALIDADE ƒ Conservar de 4 a 10°C por 4 meses. INOCULAÇÃO ƒ Estriar a superfície do meio, usando a técnica de semeadura para isolamento; ƒ No final da semeadura, picar o meio com a alça para verificar hemólise em profundidade; ƒ Incubar à 35ºC 24 horas. INTERPRETAÇÃO ƒ Cor original do meio: vermelho. ƒ Beta hemólise: presença de halo transparente ao redor das colônias semeadas (lise total dos eritrócitos). ƒ Alfa hemólise: presença de halo esverdeado ao redor das colônias semeadas (lise parcial dos eritrócitos). ƒ Gama hemólise (sem hemólise): ausência de halo ao redor das colônias (eritrócitos permanecem íntegros). RECOMENDAÇÕES ƒ Não usar sangue de carneiro vencido, pois o meio fica hemolisado ou com cor muito escura, dificultando o estudo de hemólise; ƒ Não usar sangue humano, pois alguns microrganismos não apresentam hemólise; ƒ Não adicionar o sangue na base do meio quente, pois as hemácias rompem-se, dificultando o estude de hemólise; Por ser um meio rico, o crescimento a partir de materiais biológicos em geral costuma ser abundante, sempre que necessário, isolar a colônia em estudo para os procedimentos de identificação, para não correr o risco de trabalhar com cepas misturadas. http://www.anvisa.gov.br/servicosaude/manuais/microbiologia/mod_4_2004.pdf
TSI 
https://www.americanas.com.br/produto/51855312/agar-tsi-triple-sugar-iron-agar-500g?WT.srch=1&acc=e789ea56094489dffd798f86ff51c7a9&epar=bp_pl_00_go_pla_aic_geral_gmv&gclid=Cj0KCQjwkIzlBRDzARIsABgXqV-heLOElb-RDAsjhoOVDcpsQErBj_-yPkDDG0aQnZTXlnJ_jmQzkUsaApjbEALw_wcB&i=5b6e524eeec3dfb1f8cdfb36&o=5c588c7a6c28a3cb5061960e&opn=YSMESP&sellerId=2853180000180
* Para diferenciação de microrganismos baseado na fermentação da dextrose, lactose e sacarose com produção de hidrogénio sulfeto.
* Preparo: 60g/l
Fórmula / Litro
Digestão Enzimática de Caseína.............................................. 5 g
Digestão Enzimática de Tecido Animal .................................... 5 g
Levedura enriquecida com Peptona ....................................... 10 g
Dextrose.................................................................................... 1 g
Lactose ................................................................................... 10 g
Sacarose................................................................................. 10 g
Citrato Férrico Amoniacal ...................................................... 0,2 g
Cloreto de Sódio ....................................................................... 5 g
Tiossulfato de Sódio .............................................................. 0,3 g
Vermelho de Fenol............................................................. 0,025 g
Ágar ..................................................................................... 13,5 g
pH Final: 7,3 ± 0,2 a 25°C
A fórmula pode ser ajustada e/ou suplementada conforme necessário para atender as especificações de desempenho.
https://www.hexis.com.br/produto/agar-tsi-500g
AGAR NEUTRALIZANTE D/E 500G

* Para isolamento de microrganismos de superfícies sanitizadas.
* Preparo: 54g/l
* Temperatura de armazenamento: 2º-8ºC
desta lista aqui qual é o OF ? https://www.hexis.com.br/produtos/?marca=ACUMEDIA&search=of
Metodos de semeadura 
tecnicas de semeadura
https://microimunoliga.blogspot.com/2016/08/pratica-6.html
http://www.ufjf.br/microbiologia/files/2018/04/ROTEIRO-PARA-AULAS-PR%C3%81TICAS-bacteriologia-2018-parte-02-Tecnicas-de-semadura-1.pdf
Referências bibliográficas:
- Oplustil, C.P.; Zoccoli, C.M.; Tobouti, N.R.; Sinto, S.I. Procedimentos Básicos em Microbiologia Clínica, 3ª Ed. Sarvier, São Paulo, SP, 2010.
- http://coral.ufsm.br/microgeral/Praticas/Roteito%20pratica%20semeaduras.pdf Acessado em 03 de Julho de 2013.